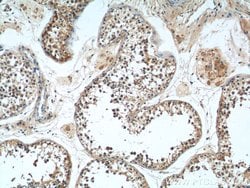
MAGEF1 Rabbit anti-Human, Polyclonal, Proteintech 150 &mu;L; Unconjugated:Antibodies,

missing translation for 'onlineSavingsMsg'
Learn More
Learn More
MAGEF1 Rabbit anti-Human, Polyclonal, Proteintech
Rabbit Polyclonal Antibody
Brand: Proteintech 24105-1-AP-150UL
This item is not returnable.
View return policy
Description
Melanoma-associated antigen (MAGE) are completely silent in normal tissues, with the exception of male germ cells, and, for some of them, placenta. These antigens ought to be strictly tumor specific, expressed in tumor cells of various histological types. Because of their specific expression on tumor cells, these antigens are of particular interest for antitumor immunotherapy. Genes of the MAGE family direct the expression of tumor antigens that are recognized on a human melanoma by autologous cytolytic T lymphocytes. Though the function of MAGE is unknown, may play a role in embryonal development and tumor transformation or aspects of tumor progression.Specifications
| MAGEF1 | |
| Polyclonal | |
| Unconjugated | |
| MAGEF1 | |
| MAGE F1 antigen, MAGEF1, melanoma antigen family F, 1, Melanoma associated antigen F1 | |
| Rabbit | |
| Antigen Affinity Chromatography | |
| RUO | |
| 64110 | |
| -20°C | |
| Liquid |
| Immunohistochemistry (Paraffin), Western Blot | |
| 0.33 mg/mL | |
| PBS with 50% glycerol and 0.02% sodium azide; pH 7.3 | |
| Q9HAY2 | |
| MAGEF1 | |
| MAGEF1 Fusion Protein Ag21147 | |
| 150 μL | |
| Primary | |
| Human | |
| Antibody | |
| IgG |
Product Content Correction
Your input is important to us. Please complete this form to provide feedback related to the content on this product.
Product Title
Spot an opportunity for improvement?Share a Content Correction